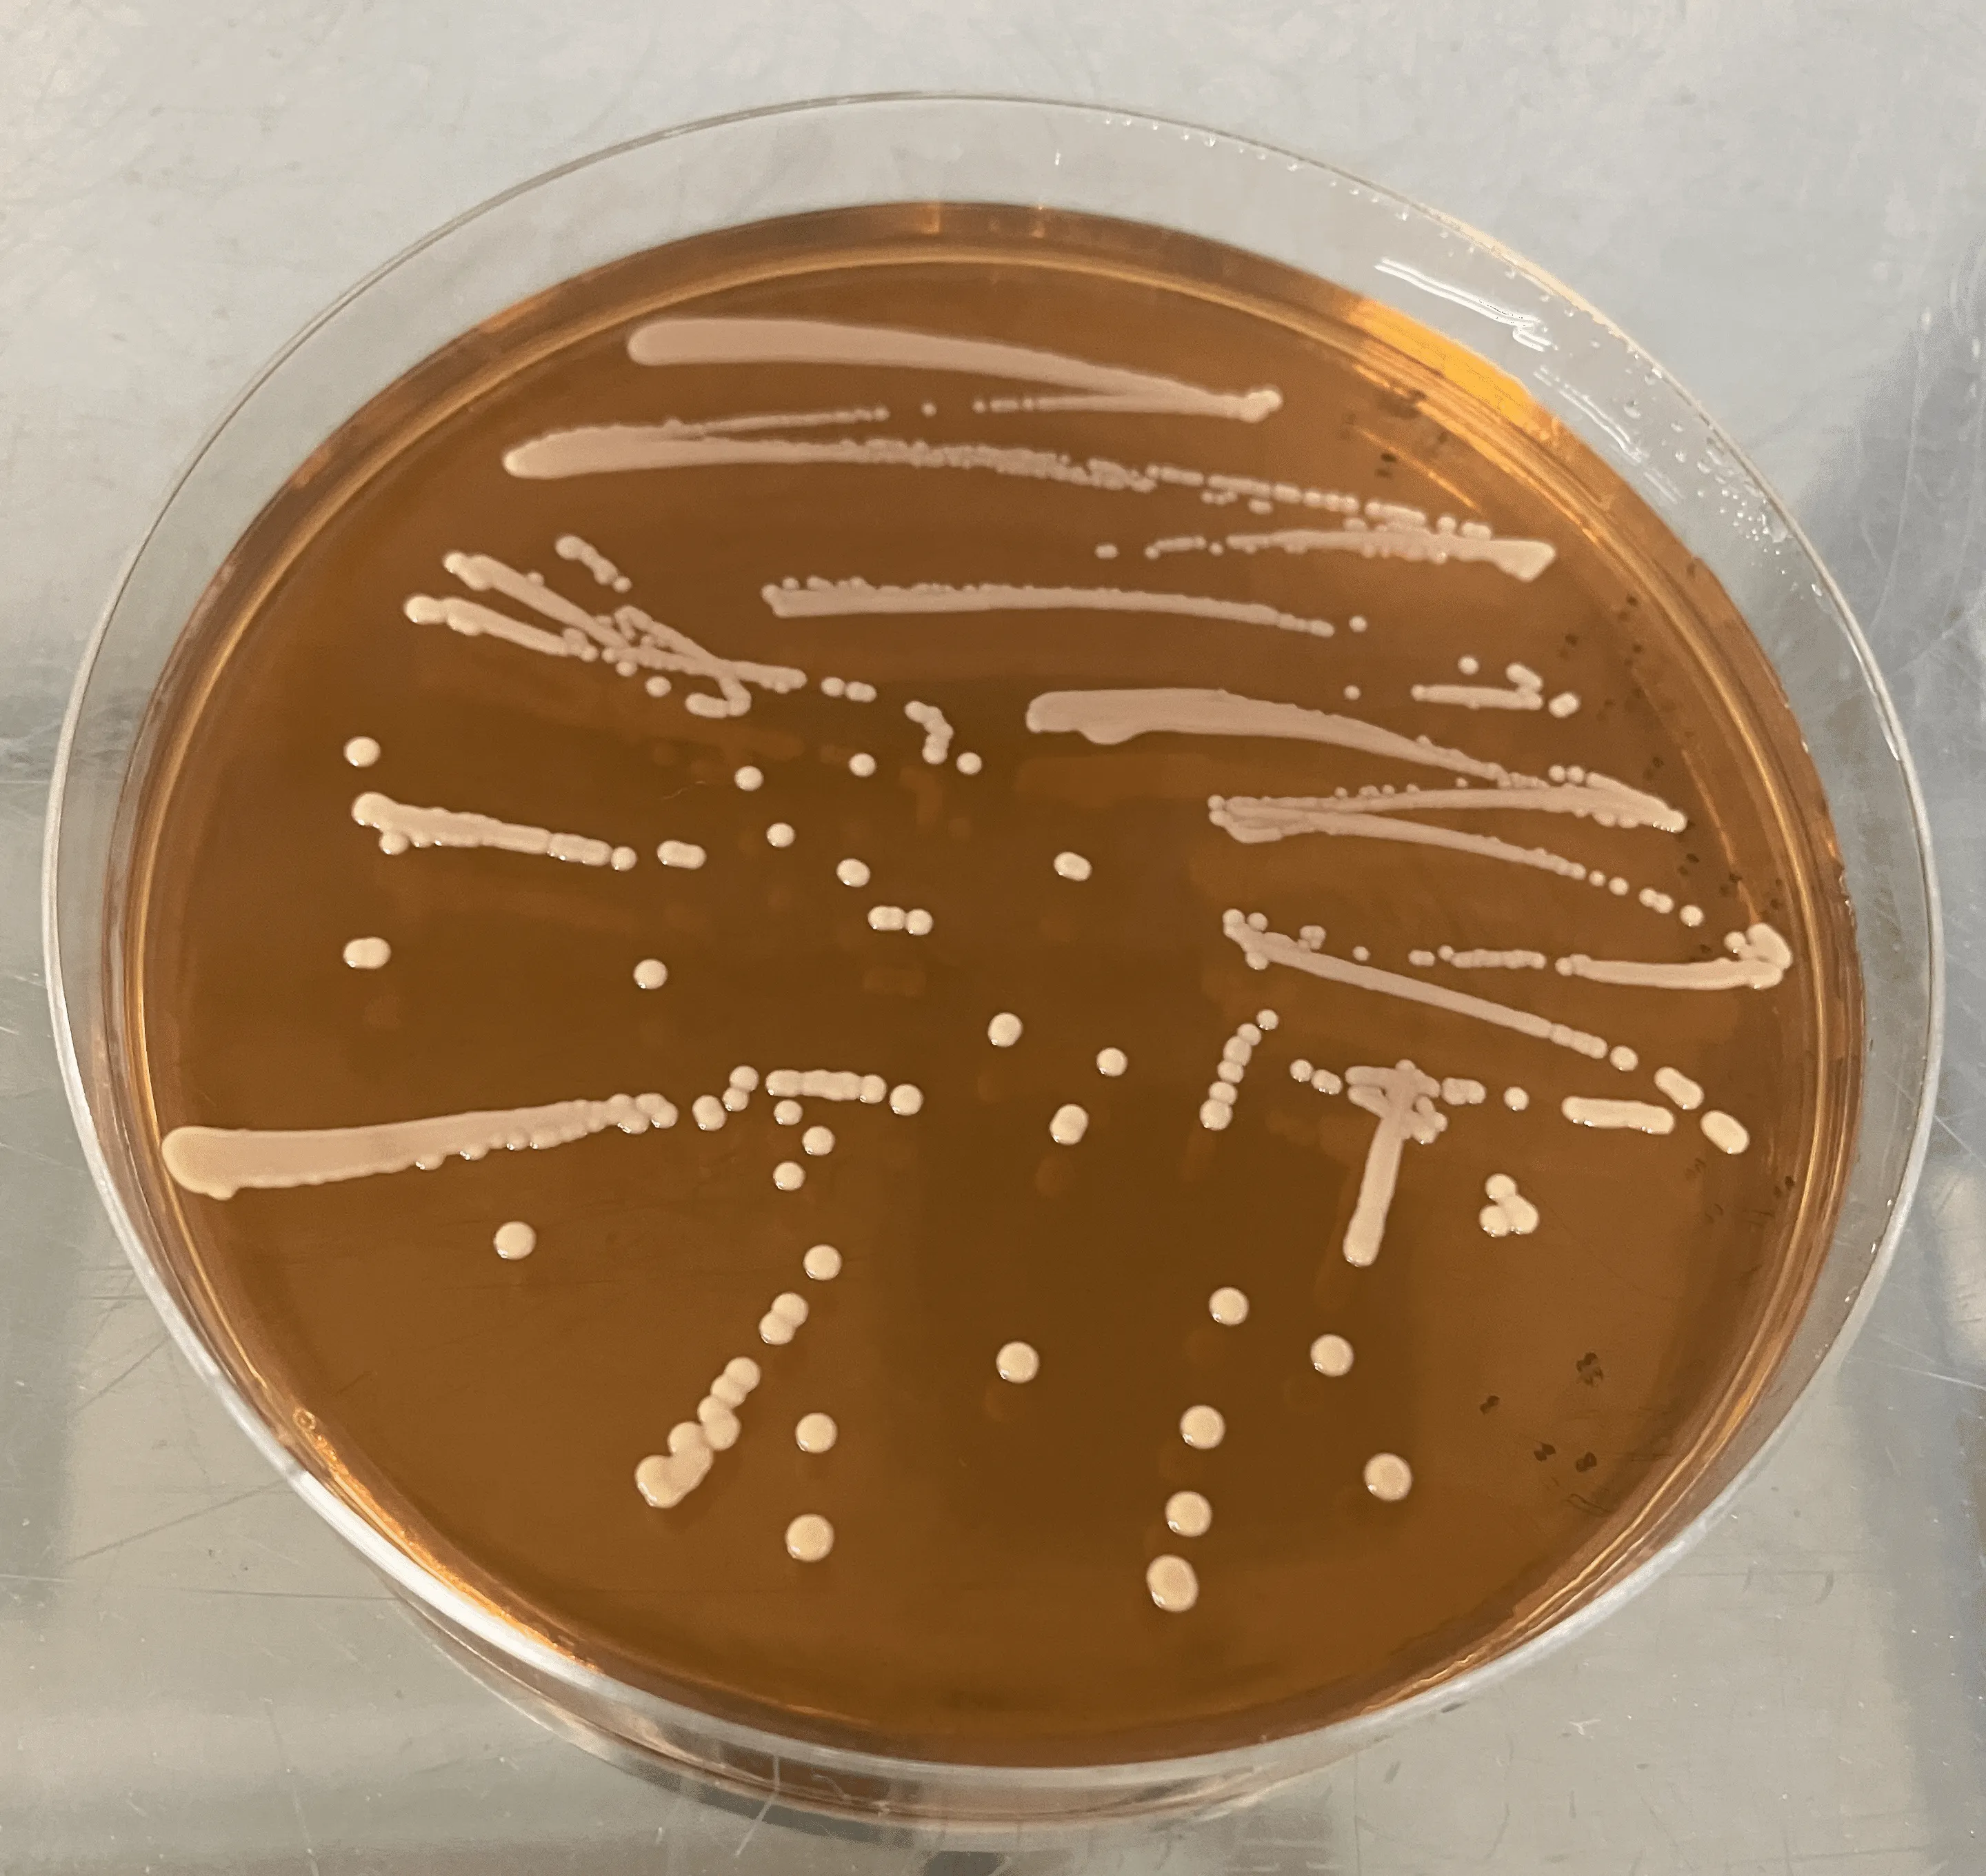

- 更新:2025年03月25日
バイオマスを活用したバイオ化学品の共同開発 未利用資源を用いたバイオ化学品の生産
BioPhenolics株式会社

- 化学
- 発酵
- 課題解決No.9「産業と技術革新の基盤をつくろう」
- プロダクト(製品)共同開発
- 共同研究
- 事業提携
- 資金調達したい
- ネットワーキング
- 大学発ベンチャー
- 地方発ベンチャー
- スタートアップ
プロジェクトメンバー
責任者
プランのアップグレードで企業責任者情報を確認いただけます
プラン詳細はこちら
自社特徴
BioPhenolicsは石油化学産業からバイオものづくり産業への転換を目指しています。
当社の技術はバイオマス(植物)を原料として改良型微生物を用いた発酵法によりバイオ化学品を生産する技術です。バイオ化学品は大気中の二酸化炭素を固定化したものであり、脱炭素製品の原料になるため、「石油を原料に使わない」「バイオマスを使う循環型資源」「大気中の二酸化炭素低減」を同時に実現することが出来ます。
当社の強みはラボ(研究)~ベンチ工場(プロセス・量産化開発)まで統合された研究開発環境を保有し、真に経済性のあるバイオ化学品の生産技術開発を行っている点です。
また、当社は硬いプラスチックの原料となる芳香族化学品を中心としたバイオ化学品事業、バイオものづくりに関するプロセス/量産開発の受託開発事業およびコンサルティング事業を行っております。
提供リソース
【製品】
芳香族バイオ化学品
(プロトカテク酸、没食子酸、カテコール、p-ヒドロキシ安息香酸、フェノールなど)
【サービス】
1,フェノリクス事業
・芳香族化学品バイオ生産技術の共同研究開発
・有償サンプル提供
2,バイオCDMO事業
・顧客が開発・所持するスマートセルを用いた受託開発/スケールアップ検討
・顧客が開発・所持するスマートセルを用いた受託培養・精製
当社ではバイオラボとベンチ工場を保有し、微生物開発、プロセス開発、量産開発を一貫して実施可能です。
解決したい課題
・芳香族バイオ化学品の共同研究開発
当社芳香族化学品のパイプライン毎にパートナーを求めております。
・パートナーへの期待
バイオ製品へのフィードバック
共同事業開発(JVなど)
資金提供(共同研究費、出資)
国プロ提案時への協力(関心表明書の提出など)
バイオ化学品事業はものづくりであるため、発酵精製工場を建設する必要があり、大資本によるサポートが必要になります。このため、当社ではBP(技術)-大企業(大資本)の組み合わせによる事業化を構想しています。
共創で実現したいこと
共創で実現したいこと
・バイオ化学品を数千トン~数万トン/年で生産する大型事業
・バイオものづくり産業の立上げ
・バイオものづくりによる循環型社会および脱炭素社会の実現
脱炭素/脱石油×循環型社会を実現させるため、当社はバイオ化学品の生産技術を開発しております。
2050年のカーボンニュートラル、さらにその先の2080年台には世界人口が100億人で飽和/安定することが予想されます。
100億人が安定的に生活できる完全循環型社会を実現させるには、今の時点から準備が必要です。
様々な技術の組み合わせが必要ですが、私たちはバイオ化学品がその一助になると考えております。
求めている条件
・化学品のバイオ化/グリーン化/GXなどを希望されている方を広く募集しております。
・大企業とスタートアップが対等であることをご理解いただける方。
・スタートアップのスピード感、資金力、制約などをご理解いただける方(あるいは理解しようとしている方)
こんな企業と出会いたい
ビジネス領域
- 化学
- グリーン・サステイナブルケミストリー
- 発酵
- 環境問題
- 課題解決No.9「産業と技術革新の基盤をつくろう」
- 総合商社
- 地球温暖化対策
オープンイノベーション実績
大手化学メーカー3社と個別に共同研究を実施しております。(非開示)
企業情報
- 企業名
- BioPhenolics株式会社
- 事業内容
- BioPhenolicsは石油化学産業からバイオものづくり産業への転換を目指しています。当社はバイオマス(植物)を原料として改良型微生物を用いた発酵法により芳香族バイオ化学品を生産する技術を開発しています。当社の強みはラボ(研究)~ベンチ工場(プロセス・量産化開発)まで統合された研究開発環境を保有し、真に経済性のあるバイオ化学品の生産技術開発を行っている点です。また、バイオ化学品のプロセス/量産開発の受託開発事業も行っております。
- 所在地
- 茨城県つくば市東光台5-5-5
- 設立年
- 2023年
プランのアップグレードで企業情報をご確認頂けます
プラン詳細はこちら